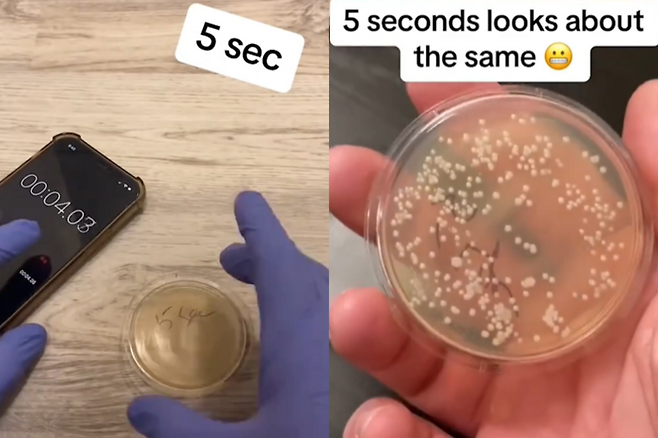
미국 시카고 품질 관리 분석 책임자인 니콜라스 아이허가 바닥에 떨어진 시간에 따른 오염도를 확인하기 위해 촬영한 영상. 사진=틱톡(@howdirtyis)캡처
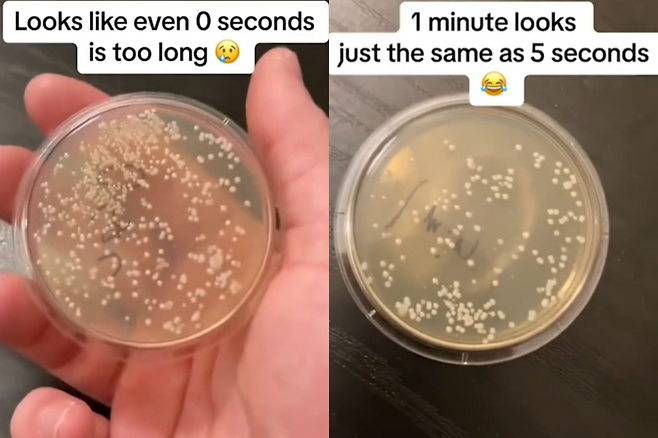
미국 시카고 품질 관리 분석 책임자인 니콜라스 아이허가 바닥에 떨어진 시간에 따른 오염도를 확인하기 위해 촬영한 영상. 왼쪽은 0초(1초 미만), 오른쪽은 1분 떨어뜨렸을 때 세균이다. 사진=틱톡(@howdirtyis)캡처

전 세계 공통 '5초룰', 진짜 5초안에 주워 먹으면 괜찮을까?
전체 맥락을 이해하기 위해서는 본문 보기를 권장합니다.
바닥에 떨어진 음식을 재빨리 주워 먹으면 괜찮다는 미신은 만국 공통이다.
영상을 본 네티즌들은 "다시는 바닥에 떨어진 음식을 먹고 싶지 않다", "당신이 내 스파게티를 망쳤다"는 반응을 보이기도 했지만 "어린 시절부터 '5초 룰' 지켰는데, 나는 아직 건강하다", "바닥에 떨어진 초콜릿 칩을 하나하나 주워 먹어 봤는데 아직 멀쩡하다"는 등 개의치 않겠다는 반응을 보이기도 했다.
이 글자크기로 변경됩니다.
(예시) 가장 빠른 뉴스가 있고 다양한 정보, 쌍방향 소통이 숨쉬는 다음뉴스를 만나보세요. 다음뉴스는 국내외 주요이슈와 실시간 속보, 문화생활 및 다양한 분야의 뉴스를 입체적으로 전달하고 있습니다.

바닥에 떨어진 음식을 재빨리 주워 먹으면 괜찮다는 미신은 만국 공통이다.
우리나라와 일본에 '3초 룰'이 있듯이 영어권 국가에서도 '5초 룰'이 있다. 이에 한 미생물학자가 실제로 5초 안에 음식을 주우면 세균으로부터 안전할지 실험해봤다.
16일(현지 시각) 영국 데일리메일에 따르면 미국 시카고 품질 관리 분석 책임자인 니콜라스 아이허는 최근 틱톡에 바닥에 떨어진 시간별로 박테리아가 얼마나 생기는지는 확인하는 실험 영상을 게재했다.
그는 각각 0초(1초 미만), 5초, 10초, 20초, 30초, 1분간 바닥에 놓아둔 세균 배양 접시를에서 얼마나 박테리아가 배양됐는지를 확인했다.
그 결과 모든 샘플에서 세균이 자라났고, 1초도 닿지 않은 샘플에서조차 세균 증식이 확인됐다.
특히 단 5초 만 바닥에 놓아 두어도 수백 개의 박테리아 군집이 생겨난 것을 확인할 수 있었다. 아이허는 “0초조차 너무 긴 것 같다. 5초든 60초든 어느 쪽이든 더럽다”면서 떨어진 시간에 상관없이 떨어진 음식은 먹지 말라고 했다.
영상을 본 네티즌들은 “다시는 바닥에 떨어진 음식을 먹고 싶지 않다”, “당신이 내 스파게티를 망쳤다”는 반응을 보이기도 했지만 “어린 시절부터 '5초 룰' 지켰는데, 나는 아직 건강하다”, “바닥에 떨어진 초콜릿 칩을 하나하나 주워 먹어 봤는데 아직 멀쩡하다”는 등 개의치 않겠다는 반응을 보이기도 했다.
또한 일부는 공기에만 노출된, 즉 바닥에 떨어뜨리지 않은 대조군이 없었기 때문에 유효한 실험이 아니라는 반응을 보였다.
한편, 전 세계에서 통용되는 '3초 룰', '5초 룰'의 기원은 정확하게 밝혀지지 않았다.
일각에서는 몽골 제국을 이끈 칭기즈칸에게서 유래했다는 설이 있다. 칭기즈칸이 연회에서 바닥에 떨어진 음식도 계속 먹으라고 요구했다는 일화가 있기 때문이다.
또, 1963년 요리 프로그램을 진행하던 줄리아 차일드가 스토브 위에 떨어진 팬케이크를 보며 시청자들에게 “아직 괜찮다”고 말한 데서 유래했다는 설도 있다.
'5초 룰'이 진짜인지를 확인하는 실험은 이전에도 있었다. 지난 2016년에는 수박, 빵, 젤리 등 여러 음식을 바닥에 떨어뜨리고 세균을 분석한 결과 음식과 바닥 표면에 따라 오염률이 다르기 때문에 모든 음식에 공통으로 적용하기 어렵다는 결과도 나왔다.
서희원 기자 shw@etnews.com
Copyright © 전자신문. 무단전재 및 재배포 금지.
- [단독]KT, 1조 투입 통합시스템 전면 개편
- 삼성전자-ASML, 반도체 공동 R&D 계획 수정…새 장소 물색
- “기업 10곳 중 3곳, AI 프로젝트 10개 이상 가동”
- 전 세계 공통 '5초룰', 진짜 5초안에 주워 먹으면 괜찮을까?
- 트럼프 정부 과학실장 “美 기술, 시간과 공간 조작 가능하다” 발언에 음모론 속출
- 기아, 첫 픽업 '타스만' 호주 상륙…포드·토요타와 정면 승부
- 임훈 후지필름코리아 사장 “사진 문화 활동 효과 '톡톡'”…10년 연속 매출 성장
- 바다에서 갓 건진 젤리?... 탱글탱글 '바다돼지' 정체는
- 반전은 없다…이재명, 충청·영남권 경선 90% 독주
- [대선 공약 톺아보기] 〈3〉AI:대전환기 국가 리더십 '바로미터'